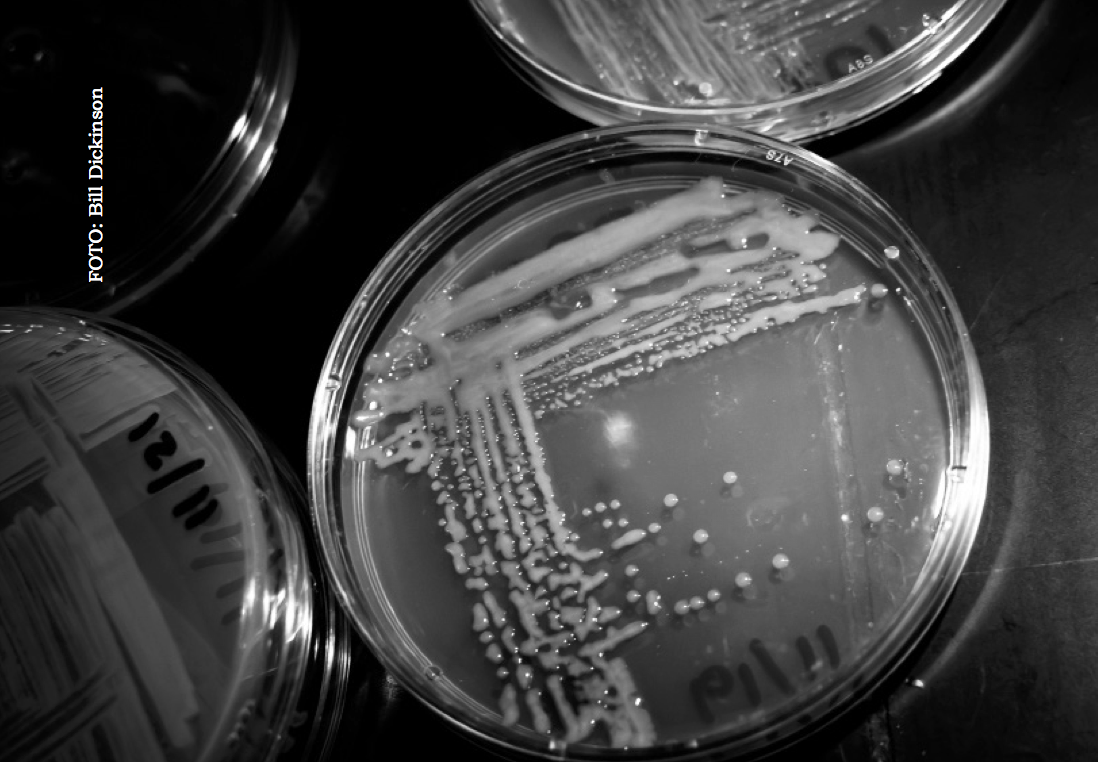

La Forja solidària d’un barri portuari és el tercer llibre de la col·lecció "Memòria Cooperativa", editada per La Ciutat Invisible. Si en els dos llibres anteriors s’analitzaven el moviment cooperatiu als barris barcelonins de Sants i el Poblenou, especialment les cooperatives obreres de consum, en aquest tercer, obra d’Emma Alari Pahissa, Santiago Gorostiza Langa i Marc Dalmau Torvà, el focus es posa en el cooperativisme a la Barceloneta. Un llibre extraordinari per descobrir el passat cooperatiu i els punts de contacte amb el moviment cooperatiu d’avui.
La Forja solidària d’un barri portuari és el tercer llibre de la col·lecció Memòria Cooperativa, iniciada per La Ciutat Invisible, ara fa set anys, amb la publicació de Les cooperatives obreres de Sants. Autogestió proletària en un barri de Barcelona, 1870-1949, d’Ivan Miró i Marc Dalmau, seguida el 2015 per Un barri fet a cops de cooperació. El cooperativisme obrer al Poblenou, també de Marc Dalmau.
Amb el primer llibre es va rescatar la història cooperativa de Sants, amb el segon la del Poblenou i ara ha tocat el torn a la Barceloneta. L’objectiu, però, és sempre el mateix: ajudar a descobrir el riquíssim moviment cooperatiu que florí a Barcelona entre la segona meitat del segle XIX i el final de la República, el 1939, un cooperativisme que, com ens mostren molt bé tots tres llibres, va ser part indestriable d’un moviment obrer i popular més ampli, dins el qual feia els rols d’aprovisionament d’aliments, espai de socialització alternativa, rereguarda de vagues i revoltes obreres i cruïlla entre diferents cultures polítiques transformadores, sobretot entre el republicanisme federal, l’anarquisme, el socialisme i el catalanisme popular.
Podem emparentar aquesta trilogia (tant de bo que aviat sigui tetralogia!) amb les obres editades per la Fundació Roca Galès o amb els treballs de Dolors Marín, Gabriel Plana, Ignasi Faura i Antoni Gavaldà, que estan recuperant la història del cooperativisme català. Uns l’han divulgat retratant els pals de paller cooperatius (Salas Anton, Micaela Chalmeta, Joan Peiró...); d’altres han explorat les relacions del cooperativisme amb el moviment llibertari o amb el nacionalisme popular català; hi ha qui ha focalitzat el seu objecte d’estudi en les cooperatives i les col·lectivitzacions al món rural i també qui ha canviat el zoom pel gran angular i ens ha donat una síntesi de l’economia social catalana. Tots ells ens han regalat aportacions ben interessants, un resultat que, a banda de la intel·ligència, la sensibilitat i l’esforç dels autors, indubtables, ha estat possible perquè, a casa nostra, hi ha hagut una quantitat tan enorme de cooperatives, i han tingut una qualitat i una diversitat tan grans, que, explorant qualsevol veta, s’hi han trobat descobertes precioses.
Dins d’aquest fons historiogràfic, els tres llibres publicats fins ara per La Ciutat Invisible se centren en el moviment cooperatiu a les barriades obreres de Barcelona, un moviment cooperatiu que tingué la seva màxima expressió en les cooperatives de consum, les quals defineixen com “societats obreres dedicades a assegurar una alimentació assequible i de qualitat per a les famílies treballadores, mitjançant la compra mancomunada a l’engròs, possibilitada per un capital social format amb les aportacions de quotes dels socis” (pàg. 23).
Les autores de La forja solidària d’un barri portuari no pretenen fer cap exercici d’erudició, sinó, com en els dos títols anteriors, oferir una arma de combat: conèixer el passat del barri per transformar el seu present, amenaçat per la turistització i la precarització, a fi de construir un futur millor. Per això també, tenim a les mans el resultat d’un treball col·lectiu d’un grapat d’anys, que deriva d’una campanya engegada el 2010 amb l’objectiu de recuperar l’edifici d’una cooperativa històrica, la Cooperativa Obrera i Popular El Segle XX, i que ha donat altres fruits com un web, una exposició, una ruta cooperativa i una monografia inèdita que, segons ens expliquen en la introducció, constitueix la llavor d’aquest llibre.
Cooperatives incrustades en la vida del barri
L’obra consta de tres parts. Les dues primeres tracten de la conformació de la Barceloneta, les condicions de vida dels seus pobladors, les principals mobilitzacions que hi tingueren lloc i la seva efervescent vida associativa, una part de la qual es desenvolupà en el si de les cooperatives. Perquè aquesta és una característica essencial de tota la col·lecció: la història del cooperativisme apareix barrejada, fusionada, dintre del relat general sobre la vida del barri, de manera que en les dues primeres parts s’explicarà l’evolució general de les cooperatives a la Barceloneta vinculant-la a la resta d’esdeveniments del barri i de la ciutat, i només a la tercera es tractarà exclusivament de l’evolució de les cooperatives, analitzades una per una.
La primera part del llibre porta per títol “La construcció d’un barri obrer i popular”. S’hi explica l’inici del barri, ideat després de la Guerra de Secessió i aixecat en pocs anys damunt la sorra del mar, així com la seva evolució des de mitjan segle XVIII, que el fa passar de ser un suburbi humilíssim de mariners i artesans, segregat de la fortalesa militar de la Ciutadella però controlat per aquesta, a esdevenir també, en el període d’entreguerres, un barri proletari de treballadors del port, el gas i el metall arribats d’altres racons del país i de la península per fer funcionar La Maquinista, la Nuevo Vulcano, o per descarregar fusta al moll, tal com recorda Papasseit.
L’aïllament de la Barceloneta i la seva densificació, que durà a subdividir els habitatges i crear els quarts de casa per encabir més i més nouvinguts, propiciaran que bona part de la vida de les famílies es faci als descampats, als carrers i a la platja, de manera que s’anirà teixint una densa trama d’iniciatives autogestionàries, adreçades les unes a millorar les condicions de treball i a defensar el dret d’associació obrera, les altres a garantir necessitats bàsiques com la salut i la previsió social, mitjançant caixes de resistència, mutualitats i monts de pietat, o com l’alimentació, mitjançant cooperatives de consum, i encara un tercer tipus que tindrà com a objectiu l’educació i l’oci, formant corals, grups excursionistes, penyes teatrals, etc.
La segona part es titula “De la revolta d’El Torín a la revolució de 1936” i recorre la història de les insurreccions, vagues i revoltes que van tenir lloc a la Barceloneta o en les quals les barcelonetines i els barcelonetins hi van participar activament. El capítol s’enceta amb la revolta a la plaça de toros del Torín, el 25 de juliol de 1835, i les bullangues que s’allargaren tot l’estiu, que van provocar la crema de convents com els de Santa Caterina i del Carme, i del vapor tèxtil Bonaplata, així com la mort del general Bassa, després que el poble assaltés el pla de Palau, i acaba amb els combats dels milicians pels carrers de la Barceloneta el 19 de juliol del 36 per fer front als colpistes. A l’entremig revivim les lluites pel dret d’associació obrera de mitjan segle XIX; la vaga revolucionària de juliol de 1909 contra la guerra del Marroc; les accions contra els tramvies des de començament del segle XX, perquè expulsaven els veïns de l’espai públic i provocaven accidents; la vaga de lloguers de 1931, i les grans vagues al port durant la Segona República.
Finalment, el llibre consta d’una tercera part que desgrana la història de les dotze cooperatives històriques de la Barceloneta, totes de consum llevat d’una de treball o producció, la Cooperativa de Treballs del Port, que tingué una existència fugaç, entre 1932 i 1934, davant del boicot a què la sotmeteren els consignataris i afeblida per les picabaralles entre ERC, que li donava suport, i la CNT, molt crítica amb les cooperatives de producció, per considerar-les “adormideras” que aburgesaven els obrers. De les onze restants, totes de consum, destacaren la Cooperativa Obrera i Popular El Segle XX i, sobretot, la Cooperativa Obrera i Popular de Consum La Fraternitat de La Barceloneta, nascuda el 1879 i sempre a l’avantguarda del moviment cooperatiu, com també fou el cas, al Poblenou, de La Flor de Maig (1890).
Així mateix, sorprèn que hi hagués una cooperativa dirigida per burgesos i militants catòlics, la Cooperativa del Centre de Nostra Senyora de Montserrat (1896-1917), i un important centre obrer amb secció cooperativa vinculat al partit radical de Lerroux, el Casino Republicà de la Barceloneta (1883-1937).
Avui dia, la dotzena de cooperatives obreres que es constituïren a la Barceloneta són totes història; unes quantes desaparegueren durant el primer terç del segle XX o al 1939, algunes altres encara sobreviurien agònicament uns quants anys a la postguerra, com la Cooperativa Popular de Consum La Barceloneta, dissolta el 1951; i un parell arribaren exhaustes fins a la transició: el Centre Cooperatiu de Pescadors (1901-1979), l’edifici de la qual és ocupat avui pel Rei de la Gamba, i La Fraternitat, liquidada el 1981, però convertit anys més tard l’edifici, modernista, en la biblioteca pública Barceloneta-La Fraternitat per part de l’Ajuntament.
Debats que ens ressonen
Al costat d’una llarga desfilada de grans realitzacions cooperatives (biblioteques, mutualitats, revistes, accions solidàries, monedes pròpies, educació d’infants i adults...), el llibre ens posa al corrent també dels debats i les contradiccions del moviment. A tall només d’exemple, esmentem l’enorme distància que sempre hi hagué entre les prèdiques i les pràctiques, entre l’ideal de cooperativitzar tota l’economia i les dificultats per compartir centrals de compra i fàbriques i magatzems propis; entre estar plenes les cooperatives de les dones dels cooperativistes, que al cap i a la fi eren les que anaven a comprar a la cooperativa, i en canvi no ser acceptades com a sòcies, en teoria fins a 1916, però a la pràctica fins una dècada després, i no poder exercir-hi càrrecs fins a la República. O entre l’ideal de la intercooperació i les dificultats per enviar delegats als espais de coordinació, per no parlar ja de no voler ni sentir a parlar de fusionar-se, les cooperatives molt petites, a fi de tenir més força. O, en fi, a la contradicció entre considerar-se, i ser-ho en gran part, instruments per a l’emancipació obrera i, al mateix temps, de vegades, actuar davant els assalariats de la cooperativa com qualsevol empresari capitalista, tal com denuncià més d’un cop la CNT. O el debat entre repartir als socis l’excedent al final de cada exercici –repartiment individual de dividends o retorn cooperatiu–, o bé destinar-lo a crear uns fons col·lectius que són els que van permetre, a mesura que aquesta opció dita moderna o col·lectiva s’anà imposant, tenir locals propis i fer tota mena d’activitats. O la persistent diferència entre una minoria cooperativista activa i “esa gran masa de mal llamados cooperadores, que no ven en nuestro movimiento nada más que el exceso de percepción y los subsidios de caràcter mutual”, segons les amargues paraules d’alguns socis de La Fraternitat (pàgina 62). És cert, però, que algunes d’aquestes contradiccions es van començar a superar, almenys en part, a partir de 1920, i d’altres al 1936, llavors ja per pura necessitat.
Completen el text principal del llibre pàgines soltes i columnes que tracten d’entitats del barri com l’Escola del Mar, el Centre Excursionista Minerva o les societats corals; la biografia sintètica de cooperativistes destacats de la Barceloneta; la reproducció de fragments de publicacions obreres de l’època; petits articles que expliquen com es van viure al barri episodis com la vaga revolucionària de 1909 o la vaga de lloguers de 1931, i altres textos breus que ens retornen ràpidament al present, com un de titulat “’La xarxa de l’amo’: contra les falses cooperatives”, o un altre d’anomenat “La repressió institucional a la venda ambulant”. Així mateix, la meitat de les tres-centes pàgines llargues que té el llibre estan il·lustrades amb fotografies del barri en aquells anys.
Tot plegat fa de La Forja solidària d’un barri portuari un gran llibre, útil, interessant i rigorós, que ens permet entendre millor l’extraordinària riquesa –contradiccions incloses– de la cultura popular i cooperativa de la qual provenim, però alhora també una obra bellíssima, estèticament parlant, d’aquelles que ens fan pensar que hi ha llibres que cap tauleta digital no podrà reemplaçar mai.
Pot ser també t’interessa
@ Deltacoop